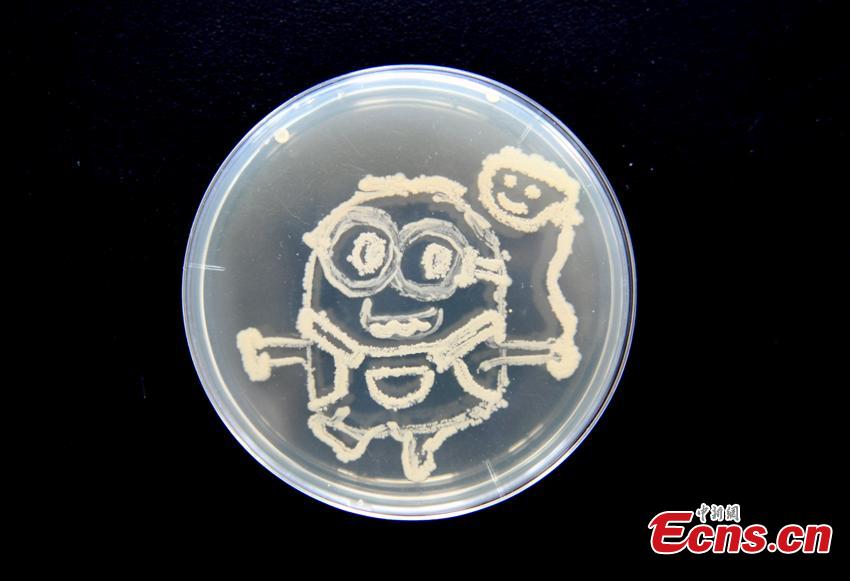

Patterns formed with bacteria are shown in petri dishes at Changchun Medical College in Changchun, Northeast China’s Jilin province. Students of the school have created artworks by placing various strains of microbes and germs into petri dishes, and letting the microbes react and spread across carefully drawn patterns. (Photo: China News Service/Zhang Yao)

Patterns formed with bacteria are shown in petri dishes at Changchun Medical College in Changchun, Northeast China’s Jilin province. Students of the school have created artworks by placing various strains of microbes and germs into petri dishes, and letting the microbes react and spread across carefully drawn patterns. (Photo: China News Service/Zhang Yao)

Patterns formed with bacteria are shown in petri dishes at Changchun Medical College in Changchun, Northeast China’s Jilin province. Students of the school have created artworks by placing various strains of microbes and germs into petri dishes, and letting the microbes react and spread across carefully drawn patterns. (Photo: China News Service/Zhang Yao)

Patterns formed with bacteria are shown in petri dishes at Changchun Medical College in Changchun, Northeast China’s Jilin province. Students of the school have created artworks by placing various strains of microbes and germs into petri dishes, and letting the microbes react and spread across carefully drawn patterns. (Photo: China News Service/Zhang Yao)

Patterns formed with bacteria are shown in petri dishes at Changchun Medical College in Changchun, Northeast China’s Jilin province. Students of the school have created artworks by placing various strains of microbes and germs into petri dishes, and letting the microbes react and spread across carefully drawn patterns. (Photo: China News Service/Zhang Yao)
Patterns formed with bacteria are shown in petri dishes at Changchun Medical College in Changchun, Northeast China’s Jilin province. Students of the school have created artworks by placing various strains of microbes and germs into petri dishes, and letting the microbes react and spread across carefully drawn patterns. (Photo: China News Service/Zhang Yao)



















